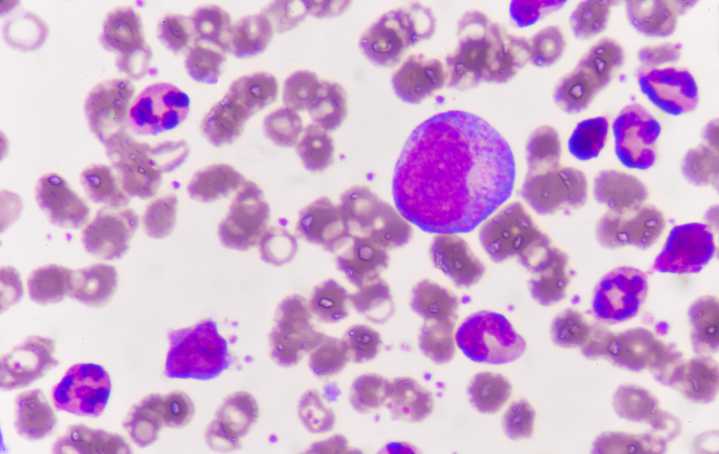

A new study led by researchers at Montefiore Einstein Comprehensive Cancer Center (MECCC) has identified genetic changes that may explain why first responders exposed to the toxic dust cloud of the September 11, 2001, World Trade Center (WTC) attacks face a higher risk of developing leukemia and other blood disorders. The findings, published in Cancer Discovery , also highlight a potential strategy to prevent or treat these diseases in people exposed to environmental toxins.
“Our findings provide new insights into the long-term health impacts of environmental catastrophes, such as wildfires, and suggest targeted interventions for those affected by 9/11 or similar disasters,” said study leader Amit Verma, MD, associate director for translational science at MECCC.
Toxic dust and blood

 Inside Precision Medicine
Inside Precision Medicine
America News
America News Raw Story
Raw Story NBC Southern California
NBC Southern California CNN
CNN NBC News
NBC News POPSUGAR
POPSUGAR The Conversation
The Conversation The US Sun Health
The US Sun Health The Hill
The Hill